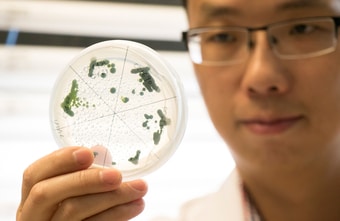

Die Hamburger Influencer-Marketing-Agentur Lucky Shareman holt sich weibliche Verstärkung aus den eigenen Reihen in die Geschäftsführung: Katharina Backenberg verantwortet ab sofort die Bereiche Personal, Finanzen und New Business. Lucky Shareman wurde 2015 gegründet und zählt heute deutschlandweit zu den führenden Experten im Influencer Marketing.
Backenberg begann ihre Karriere bei Lucky Shareman vor über fünf Jahren als Trainee. Aufgrund ihres Engagements und Talents wurde die studierte Betriebswirtin bereits nach wenigen Monaten frühzeitig übernommen und arbeitete als Beraterin für Influencer Marketing. Schon zwei Jahre später übernahm sie die Leitung Operations und Beratung und wurde nur kurze Zeit darauf zusätzlich Mitglied der Geschäftsleitung. Während ihrer Laufbahn bei Lucky Shareman lag der Fokus der 27-Jährigen darauf, das Team neu aufzubauen, Angebotsmodelle sowie Prozesse weiterzuentwickeln und Strukturen im Unternehmen zu schaffen.
"Uns konnte nichts Besseres passieren"
Trotz ihrer neuen Rolle als Geschäftsführerin wird sie auch weiterhin Kund:innen und deren Kampagnen betreuen. "Mir ist wichtig, dass ich im aktiven Austausch mit unseren Kund:innen bleibe. Das hilft mir dabei, Prozesse nachzuvollziehen und in meiner neuen Position zu optimieren. Ich identifiziere mich zu 100 Prozent mit dem Team, die tägliche Zusammenarbeit macht mir Spaß – und das soll unbedingt so bleiben", betont Backenberg.
"Uns konnte nichts Besseres passieren, als eine Geschäftsführerin, die sowohl die Agentur als auch das Team selbst seit Jahren kennt", erklärt Björn Wenzel, Gründer und bisher alleiniger Geschäftsführer von Lucky Shareman. Aus bisherigen Erfahrungen habe man im Unternehmen gelernt: Statt externe Führungskräfte an Bord zu holen, werden lieber interne Talente gefördert und entwickelt, die mit Prozessen und Strukturen vertraut sind. "Mit Katharina Backenberg sind wir jetzt auch in der Geschäftsführung ein richtiges Team. Mehrere Köpfe bedeuten auch mehrere Perspektiven und mehr Ideen – das ist vor allem heutzutage unerlässlich", fügt Wenzel hinzu.
www.luckyshareman.com





































 >
>

Kommentar veröffentlichen